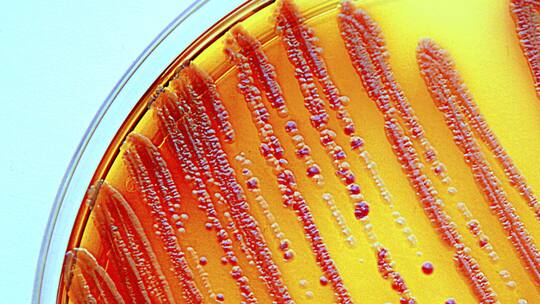
Der Kampf gegen die Resistenzen

Der Kampf gegen die Resistenzen
In Schweizer Spitälern sterben täglich Menschen wegen resistenter Keime. Resistenzen machen die neusten Antibiotika wirkungslos.
Veröffentlicht am 31. Oktober 2011 - 08:26 Uhr
Gefährliche Klebsiellen: Die Darmbakterien sind gegen neuste Antibiotika resistent.
Ärzte sind krank machende Bakterien eigentlich gewohnt. Doch was die Infektiologen auf der Intensivstation des Universitätsspitals in Basel zu sehen bekamen, trieb selbst ihnen den Puls in die Höhe. Der ausserordentliche Fall ereignete sich 2010: Ein Patient mit Magen-Darm-Beschwerden entwickelte eine fiebrige Infektion, die sich mit gängigen Antibiotika nicht eindämmen liess. Das kommt zwar immer wieder vor, doch stiessen die Ärzte in diesem Fall auf eine für die Schweiz neue Form einer Resistenz. «Wir identifizierten eine hochgefährliche Multiresistenz vom Typ KPC», sagt Reno Frei, Leiter des Mikrobiologie-Labors.
Die Resistenz stammt aus Darmbakterien des Typs Klebsiella pneumoniae und schaltet gängige Reservemedikamente vom Typ der Carbapeneme aus, deshalb die Abkürzung KPC. Wenn andere Antibiotika versagen, sind diese Mittel für gewöhnlich der letzte Rettungsanker. Der schwerkranke Mann aber erholte sich nicht mehr und verstarb an einem Multiorganversagen. Die Todesursache führt Reno Frei hauptsächlich auf den multiresistenten Keim zurück, den der Mann in einem italienischen Spital aufgelesen haben dürfte.
Der beängstigende Fall zeigt, wieso wir dringend neue Antibiotika benötigen. «Die Resistenzprobleme laufen aus dem Ruder», sagt Andreas Widmer, Professor am Universitätsspital Basel und Leiter der Spitalhygiene. Mit dieser pessimistischen Sicht ist er nicht allein. Weltweit warnen Ärzte und Patientenorganisationen vor der Ausbreitung neuer Resistenzen und appellieren an die Forscher in der Pharmaindustrie, neue Mittel zu entwickeln. Angesichts des drohenden Notstands ruft der Franzose Patrice Nordmann, einer der profundesten Kenner und Erforscher der KPC-Resistenzen, zu drastischen Massnahmen auf: Allein beim Verdacht auf diese Resistenz sollen mögliche Träger isoliert werden. Das Personal muss Schutzkleider und -masken tragen. In den Universitätsspitälern Zürich und Basel werden diese Sicherheitsmassnahmen bereits umgesetzt.
Der dramatische Verlust der antimikrobiellen Wirkung der Medikamente markiert einen Tiefpunkt im Kampf Mensch gegen Mikroben. Dabei sind erst 70 Jahre vergangen, seit mit den Antibiotika eine vermeintliche Wunderwaffe gegen die krank machenden Keime entwickelt wurde. Im Frühling 1941 spritzte der britische Arzt Charles Fletcher einem todkranken Patienten erstmals das Antibiotikum Penicillin. Der schottische Arzt Alexander Fleming entdeckte den Naturstoff 1928 bei seiner Arbeit mit Bakterien im St.-Mary’s-Krankenhaus in London. Als er zufällig alte Kulturen erblickte, die er entsorgen wollte, bemerkte er ein auffälliges Muster. Ein Schimmelpilz – Penicillium notatum – hatte die Kulturplatten befallen, und um die stecknadelkopfgrossen Kolonien herum wuchsen keine Bakterien mehr.
Fleming kombinierte weitsichtig: Der Pilz produziert eine Substanz, die das Wachstum der Bakterien hemmt. Er untersuchte den Pilz und beschrieb die antibakterielle Wirkung des Stoffs, den er Penicillin nannte. Erst Jahre später gelang es dem Arzt Howard Florey und dem Chemiker Ernst Chain, den Stoff zu reinigen und in nutzbaren Mengen herzustellen. Ihre Arbeiten sind ein Meilenstein der modernen Medizin. Anfang der vierziger Jahre begann der Siegeszug des Penicillins bei der Bekämpfung von Infektionskrankheiten wie der Syphilis oder der Tuberkulose. 1945 erhielten die drei Entdecker dafür den Nobelpreis für Medizin.

Vater des Penicillins: Der schottische Arzt Alexander Fleming entdeckte 1928 das Antibiotikum.
Dass die Mikroben den Angriff abwehren würden, dachte damals niemand. Mittlerweile bilden die Mikroben in immer kürzeren Abständen Resistenzen und degradieren die einst potenten Medikamente zu harmlosen Zuckerpillen. Bakterien sind wahre Meister im Erfinden von Abwehrstrategien. Weil sich die Keime rasch vermehren, produzieren sie laufend mutierte Varianten. Immer wieder ist dabei eine Form darunter, die auch neuste Antibiotika ausschalten kann. Ein verhängnisvoller Kreislauf wird in Gang gesetzt: Wird ein kranker Mensch mit diesem Wirkstoff behandelt, gedeihen in seinem Körper genau jene mutierten Krankheitskeime, die den Wirkstoff unschädlich machen können. Die Mutante wird gefördert. Die Resistenzen breiten sich durch Austausch unter Bakterien rasch aus.
Das Problem liegt dabei auch in der Natur der Sache: Antibiotika haben bei Mikroorganismen die gleiche Aufgabe wie das Immunsystem beim Menschen. Sie schützen Pilze vor Bakterien. Es ist deshalb nur logisch, dass in der Natur auch Bakterien vorkommen, die seit Urzeiten gegen Antibiotika resistent sind.
Ein kanadisches Forscherteam hat kürzlich solche Keime gefunden. Die Forscher haben aus dem Permafrost in Yukon Mikroben isoliert, die über 30'000 Jahre alt sind und nie mit modernen Medikamenten Kontakt hatten. Trotzdem sind sie resistent gegen eine Reihe verschiedener Antibiotika. Sie bewiesen, dass Resistenzen ein natürliches Phänomen seien, sagt Gerry Wright von der McMaster-Universität in Hamilton.
Seit Flemings Penicillin kämpfen Ärzte und Forscher gegen dieses Phänomen an. Sie haben in den letzten Jahrzehnten Hunderte von Abkömmlingen der Penicilline entwickelt. Die Keime antworten mit ebenso vielen Varianten von Resistenzen. Das gilt auch für die Nachfolger der Penicilline wie zum Beispiel die Cephalosporine, die der sardische Arzt Giuseppe Brotzu bereits 1945 aus dem Schimmelpilz Cephalosporium acremonium isolieren konnte.
Gefährlich unter den Resistenzen sind etwa die MRSA, die sich in den achtziger Jahren weltweit auszubreiten begannen. Die Abkürzung bezieht sich auf Staphylococcus aureus, allgegenwärtige Bakterien auf der Haut, die resistent sind gegen das Antibiotikum Methicillin. MRSA haben hierzulande und weltweit unzählige und teils tödliche Spitalinfektionen ausgelöst und sich einen zweifelhaften Ruf als «Spitalkäfer» geschaffen.
Während sich in der deutschen Schweiz das MRSA-Problem entschärft hat, bereitet den Ärzten eine Resistenz mit der Abkürzung ESBL zunehmend Probleme. Die in der Öffentlichkeit noch wenig bekannte Resistenz tauchte Anfang der achtziger Jahre erstmals auf. ESBL steht für Extended-Spectrum-Beta-Lactamase und besagt, dass die Resistenz ein breites Arsenal von Antibiotika unschädlich macht. Darunter zum Beispiel die Penicilline und Cephalosporine sowie ihre Abkömmlinge.
Alle diese Medikamente verlieren ihre Wirkung, wenn die Keime eine ESBL-Resistenz besitzen. Sie bereitet den Ärzten deshalb Sorgen, weil sie häufig vorkommt und weitverbreitete Keime wie die Kolibakterien oder Klebsiella pneumoniae betrifft. Beide Arten besiedeln den Darm und können dort die Resistenzen einfach untereinander austauschen. Befallen sie hingegen die Atem- oder Harnwege, kommt es zu Infektionen. Hat man das Pech, mit einem Keim dieses Resistenztyps angesteckt zu werden, helfen nur noch intravenös verabreichte Antibiotika vom Typ der Carbapeneme. Selbst an sich harmlose Blaseninfektionen können so zur tödlichen Bedrohung werden.
Fachleute der Universität Bern bezeichnen ESBL-Resistenzen als grosses Problem in der Schweiz. In den letzten Jahren haben sich Fälle des ESBL-Resistenztyps vervielfacht. Im Zürcher Unispital wurden 2010 161 Proben registriert. Vor acht Jahren waren es noch 30. ESBL-Resistenzen sind hochproblematisch, weil sie sich in der Bevölkerung schleichend ausbreiten - sechs Prozent sind bereits Träger dieser Resistenz. Im Kot von Hühnern findet man in 69 Prozent der Proben die gefährlichen Resistenzmerkmale.
Als wäre dies nicht genug, tauchen auch in der Schweiz KPC-Resistenzen auf. Typisch sind Fälle von Patienten, die den Superkeim in einem ausländischen Spital aufgelesen haben. Sie machen die Reservemedikamente wirkungslos, auf die Ärzte zurückgreifen, wenn Keime mit der Breitbandresistenz vom ESBL-Typ auftauchen. Noch sind es Einzelfälle. Doch Erfahrungen in Ländern wie Griechenland, Italien oder den USA zeigen, dass sie sich rasch ausbreiten können.
Die Natur ist dem Menschen einen Schritt voraus. Vor sechs Jahren isolierte der britische Infektiologe Timothy Walsh aus einem schwedischen Patienten Darmbakterien, die bereits eine neue Resistenzform gegen Carbapeneme trugen. Walsh benannte sie nach der Herkunft NDM-1, denn der Patient hatte die Infektion im indischen Neu-Delhi aufgelesen.
Britische Ärzte konnten eine Reihe von Patienten mit diesen resistenten Keimen in Europa ausfindig machen. Dabei handelte es sich um Kosmetiktouristen, die wegen plastischer chirurgischer Operationen nach Indien gereist waren. Walsh spekulierte auf eine grössere Verbreitung der NDM-1-Resistenz in Indien und sammelte Wasserproben in Neu-Delhi. Sowohl in der Kanalisation als auch in öffentlichen Brunnen entdeckte er die heimtückischen Bakterien. Die Resistenz lässt sich unterdessen auch auf Krankheitserregern wie dem Cholerabakterium nachweisen.
In der Schweiz ist NDM-1 bisher nur vereinzelt aufgetaucht. Wie bei KPC unternehmen die Spitäler alles, um eine Ausbreitung zu stoppen, da eine Harnblaseninfektion mit NDM-1-Keimen kaum mehr zu behandeln ist.
Die Schreckensmeldungen aus Indien zeigen einerseits den verhängnisvollen Zusammenhang zwischen mangelnder Hygiene und der Ausbreitung von resistenten Keimen in der Umwelt. Anderseits ist die Pharmaindustrie an der Misere mitschuldig. Die grossen Unternehmen haben sich aus der Erforschung dieses Gebiets weitgehend verabschiedet. Es ist lukrativer, Blutdruck- oder Cholesterinsenker zu verkaufen, die Patienten während Jahren schlucken müssen, als vorübergehend anwendbare Antibiotika. Zwischen 1950 und 1980 sind weltweit 200 neue Antibiotika auf den Markt gebracht worden, in den letzten zehn Jahren war es nur noch eine Handvoll.
Typisches Beispiel für diese Entwicklung ist die Basler Pharmafirma Roche: Sie gliederte vor 14 Jahren ihre traditionelle Antibiotika-Forschung in die Firma Basilea aus. Der kleinere Betrieb hat zwar Antibiotika in Entwicklung, doch die Projekte kommen nur schleppend voran. Roche macht derweil Kasse mit Krebsmedikamenten, die Hunderttausende von Franken pro Patienten kosten.
Wegen der prekären Situation starteten amerikanische Infektiologen die Initiative «10 by 20» mit dem Ziel, bis 2020 zehn neue Mittel auf den Markt zu bringen. Gefragt sind Ideen, wo neue Stoffe zu finden sind, die Mikroben wirksam töten, ohne den Menschen in Gefahr zu bringen. Also antimikrobielle Stoffe aus Organismen, die sich entwicklungsgeschichtlich weit weg vom Menschen befinden, aber über ein gut ausgebildetes Abwehrsystem verfügen. Die Antibiotika-Jäger suchen in exotischen Organismen wie dem Bachneunauge oder dem Känguru.

Der Australier Ben Cocks zum Beispiel untersucht das putzige Derbywallaby (Känguru-Art Macropus eugenii) nach möglichen Wirkstoffen. Weil es die Neugeborenen in einem unhygienischen Beutel mit sich trägt, rechnet er sich gute Chancen auf brauchbare Stoffe aus. Andere Forscher setzten auf das urtümliche Schnabeltier, das Eier legt und mit seinem breiten Schnabel im Wasser nach Würmern fischt. Vielleicht hilft uns das eierlegende Säugetier mit dem auffälligen Kopf aus der Antibiotika-Misere. Rasche Hilfe ist aber nicht zu erwarten. Die Entwicklung neuer Medikamente benötigt mindestens zehn Jahre. «Die Resistenzen haben uns eingeholt», sagt der Professor und Basler Spitalhygieniker Andreas Widmer, «die Mikroben sind geschickter.»
Spitalinfektionen: 1000 Todesfälle pro Jahr
Wegen einer Lungenentzündung suchte Lukas Leicht (Name geändert) eine Zürcher Klinik auf und infizierte sich dort mit einem multiresistenten Keim. Der Infekt führte zu einer Entzündung des Herzbeutels und zog mehrere Operationen, drei Monate Spitalaufenthalt und eine längere Rehabilitation nach sich. Die Spitalinfektion sei zwar ein gravierender Fall, wie Barbara Züst von der Schweizerischen Patientenorganisation (SPO) erklärt – aber beileibe nicht der einzige. Genaue Zahlen fehlen, doch rechnen Fachleute in der Schweiz mit jährlich rund 100'000 Spitalinfektionen. Rund 1000 davon verlaufen tödlich. Laut Weltgesundheitsorganisation (WHO) sterben in der EU jedes Jahr geschätzte 25'000 Patienten wegen Infektionen mit resistenten Keimen, die sie im Spital aufgelesen haben.
Multiresistente Bakterien vom Typ Staphylococcus aureus (MRSA) haben sich einen zweifelhaften Ruf als «Spitalkäfer» geschaffen. Sie können gefährliche Wundinfektionen nach Operationen auslösen. Die Resistenz hat sich in den Spitälern seit den achtziger Jahren weltweit explosionsartig verbreitet und zu unzähligen Leidensgeschichten geführt. 2007 haben sich in der EU knapp 28'000 Menschen mit MRSA infiziert. Am meisten Menschen erkrankten in Portugal, Grossbritannien und Frankreich, am wenigsten in Island und Norwegen. 20 Prozent der Fälle verliefen tödlich.
Genaue Zahlen liegen für die Schweiz nicht vor, doch mehrere tausend MRSA-Infektionen dürften auch hierzulande jährlich auftreten. Überraschend sind die Unterschiede in den Sprachregionen: In den Spitälern der französischen Schweiz sind bei Routineuntersuchungen rund 30 Prozent der Patienten mit MRSA infiziert, in der Deutschschweiz nur drei Prozent – zehnmal weniger. Das Problem hat sich zumindest in der Deutschschweiz entschärft, und die Spitäler sind der Meinung, sie hätten dieses Problem im Griff. Worauf die Unterschiede zurückzuführen sind, ist allerdings nicht klar. Denn die aufgrund des Spitalkäfer-Problems eingeführten Hygiene- und Isolationsregeln gelten in der ganzen Schweiz. Möglich ist, dass die höheren Infektionsraten in der Westschweiz Resultat eines freizügigeren Umgangs mit Antibiotika sind. Wie die Südländer neigen auch die Romands schneller als die Deutschschweizer dazu, Antibiotika zu schlucken. Des Weiteren dürfte es sich auch um eingeschleppte Fälle aus Frankreich handeln. Anfang 2011 machte in der Westschweiz eine weitere Resistenzform Schlagzeilen. In Payerne führten gegen das Antibiotikum Vancomycin resistente Darmbakterien dazu, dass das Interkantonale Spital der Broye (HIB) vorübergehend geschlossen werden musste.
Unabhängig davon, ob die Keime gegen Antibiotika resistent sind oder nicht: Spitalinfektionen sind ein gravierendes Problem. Rund zwölf Prozent der Patienten infizieren sich im Spital. Sowohl auf Seiten der Spitäler wie der Patienten braucht es laut den Verantwortlichen mehr Bemühungen, die Infektionsraten zu senken: Kontrolle möglicher Träger, ihre Isolation und pedantische Hygiene bei Mitarbeitern und Patienten.

Weitere Infos
- Das BAG zum Thema «Antibiotikaresistente Bakterien»: www.bag.admin.ch
- Stiftung SPO Patientenschutz: www.spo.ch